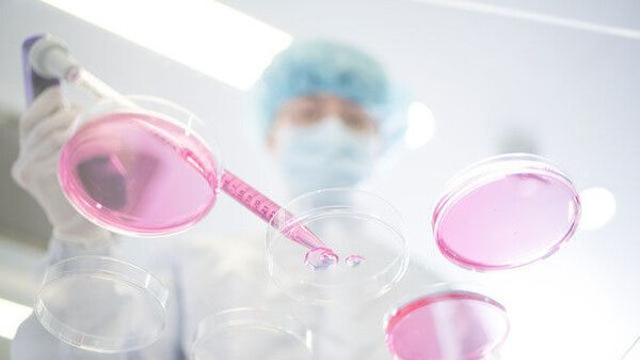
thumbimg

⚡ 뉴스 pick
- AI가 바꾼 광산업계…'구리 확보 전쟁'에 메가 M&A 봇물
- 2026.01.12 [이데일리]
- 구글-월마트 'AI 쇼핑' 손잡아…"챗봇과 대화중 상품 결제 가능"
- 2026.01.12 [연합뉴스]
- 그린란드인들 "우리는 미국인도 덴마크인도 되고싶지 않다"
- 2026.01.12 [프레시안]
- '성공적 방중' 뒤에 남은 이재명 정부의 세가지 과제
- 2026.01.12 [프레시안]
- 트럼프 그린란드 야욕에도 나토는 침묵…유럽 동맹국들 불만
- 2026.01.12 [모두서치]
- 美국토안보장관, 'ICE 총격 시위' 미네소타에 "법집행인력 추가 파견"
- 2026.01.12 [모두서치]
- 중부지방 곳곳 눈비…"경기북동부 2∼7㎝"
- 2026.01.12 [아주경제]
- ‘강선우 1억 의혹’ 김경, 3시간 반 경찰 조사 뒤 귀가…조만간 재소환
- 2026.01.12 [위키트리]
- 지난해 수도권매립지 생활폐기물 총량제 '준수'…반입량 최저
- 2026.01.12 [연합뉴스]
- 트레킹 코스부터 맛집까지…'서초 관광 가이드북' 발간
- 2026.01.12 [연합뉴스]
- '새로운 작용' 비만 치료제 올해 나올까…빅파마 쟁탈전
- 2026.01.12 [모두서치]
- ‘K패션 간판’ 코오롱FnC마저…업계에 몰아친 구조조정 칼바람
- 2026.01.12 [이데일리]
- 연수 중 배드민턴 치다 쓰러진 교사…法 "공무상 재해 인정 안돼"
- 2026.01.12 [모두서치]
- 덴마크 국방위원장, 그린란드 군사충돌시 "역사상 가장 멍청한 전쟁" 될 것
- 2026.01.12 [모두서치]
- 연수 중 배드민턴 치다 쓰러진 교사…법원 "공무상 재해 아냐"
- 2026.01.12 [연합뉴스]
- 정부24, 연말정산용 증명서 발급 전용 창구 개설
- 2026.01.12 [뉴스로드]
- 경기 일부 지역 오전부터 눈비…내일까지 1~7㎝ 예상
- 2026.01.12 [연합뉴스]
- 전북 북동부 한파주의보…낮 3~6도, 밤에 눈과 강풍
- 2026.01.12 [모두서치]
- 광주·전남 이틀간 최대 25㎝ 적설…빙판길 유의
- 2026.01.12 [모두서치]
- 홍준표 "배현진 인성이…" vs 배현진 "노년에 집중하시길"
- 2026.01.12 [이데일리]